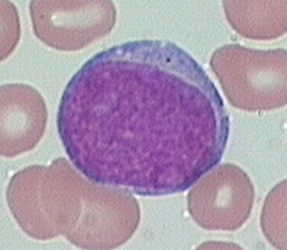
<p>High N:C ratio of 8:1 to 4:1. Basophilic cytoplasm with fine nuclear chromatin. 2 to 4 visible nucleoli. No visible granules or the presence of a few dispersed primary (azurophilic) granules in the cytoplasm</p>

1/90
Looks like no tags are added yet.
Name | Mastery | Learn | Test | Matching | Spaced | Call with Kai |
|---|
No study sessions yet.
Cluster of Differentiation (CD) antigens
Acts as receptors or signal transfucers. Used to identify specific cell types by species, lineage, maturation stage, state of activation
Lineage specific CD
Example includes CD3 which is found only on T cells - NK ad B cells lack CD3
Maturation specific CD
Example includes immature T cell thymocytes are CD4- and CD8-, then goes through a CD4+/CD8+ phase then eventually are only CD4 or CD8+
Activation specific CD
Example includes how all B cells are CD20+ but plasma cells (activated B) are CD20-, or how activated T cells express CD56
Hematopoietic stem cells (HSC)
Pluripotential. Will either divide (self-renew), differentiate or die (apoptosis)
Colony forming units (CFU)
Groups of progenitor cells, including common myeloid progenitor and common lymphoid progenitor
Cytokines
LMW soluble proteins that stimulate or inhibit differentiation, movement, growth and production of leukocytes. Produced by leukocytes and non-hematological cells
Colony-stimulating factors (CSF)
Type of cytokine. Promotes division and differentiations. Has specific targets
Interleukins (IL)
Type of cytokine. Multiple biologic activities, sources and targets. Interact with other cytokines
Neutrophil development
Develops and matures in pools in BM. Share a common progenitor with monocytes (granulocyte-monocyte progenitor - GMP). The majoy cytokine responsible for the stimulation of production is G-CSF (granulocyte)
Marginating pool
Where cells loosely adhere to vessel endothelium. Enter tissue in reponse to chemotaxis. First to arrive when extra granulocytes are needed.
Circulating pool
Where cells circulate until eventually entering the tissues. Function does not differ between the pools
Myeloblast
High N:C ratio of 8:1 to 4:1. Basophilic cytoplasm with fine nuclear chromatin. 2 to 4 visible nucleoli. No visible granules or the presence of a few dispersed primary (azurophilic) granules in the cytoplasm
Promyelocyte
Larger than the myeloblast. Nucleus is round to oval and is often central (chromatin clumping may be visible). Characteristic abundance of azurophilic primary granules. One to three nucleoli present but may be obscured by granules

Myelocyte
Early stage looks very similar to the promyelocyte in size and nuclear characteristics except patches of grainy pale pink cytoplasm (secondary granules) becomes more evident near Golgi. Primary granule per cell decrease as cell divides and are less visible. Late stage are bit smaller than promyelocyte, nucleus more clumped, and nucleoli are difficult to see by light microscopy

Metamyelocyte
Cells no longer divide from this point on. Nucleus is indented (kidney or peanut shaped). Chromatin is increasingly clumped. Nucleoli are absent. Size is slightly smaller than myelocyte. Cytoplasm contains very little residual RNA - little to no basophilia

Band neutrophil
Evidence of RNA (cytoplasmic basophilia) is absent. Nucleus is highly clumped. Nuclear identation that began in the metamyelocyte stage now exceeds one half the diameter of the nucleus. Actual segmentation not yet occured
Neutophil
7% to 30% of nucleated cells in the BM - secretory granules continue to be formed during this stage. Released into PB when mature (some bands released) and travel by PB until required in tissue anywhere in body. Dies by apoptosis if not needed, and if needed, life is prolonged by cytokines
Neutrophil function
Phagocytosis and destruction of foreign material and microorganism. Part of the innate immune response - receptor to omplement and Ig and can phagocytose bacteria fungus and yeast. Attracted (recruited) by chemokines. Anaphylatoxin increased vascular permeability to encourage diapedesis.
Eosinophil
1-3% of nucleated cells in BM. Develops and matures in pools in BM. Similar maturation stage as neut. Released from BM storage pool into PB. Can increase release quickly in times of need. Circulate in PB then travel to tissue - mainly beneath columnar epithelial cells in resp, GIT and genitourinary tracts.
Eosinophil function
Helps with immune regulation by releasing cytokines and act as antigen presenting cells to promote proliferation of T cells. Participates in allergic reaction where # in PB and sputum correlates with disease severity. Mediates parasitic infection through secretions of MBP, cationic protein and ROS
Eosinophil granules
Includes major basic protein (MBP), eosinophil cationic protein, peroxidase, lysozyme, catalase, GM-CSF, interleukins.
Classical & compound exocytosis
Eosinophil degranulation by single or fused granules merge with plasma membrane.
Piecemeal degranulation
Eosinophil degranulation through vesicles removing only specific proteins from granules
Cytolysis
Eosinophil degranulation by depositing intact granules to tissue through cell death
Basophil
<1% of nucleared cells in the BM. Develops and matures in BM. Released to PB for short circulation then enter tissues. Most found in blood, spleen or at site of inflammation in tissue. Production ‘linked’ to mast cell but not same cells.
Basophil function
poorly understood function. Involved in hypersensitivity reactions. Granule contents not fully understood and can change production based on specific activation signals. Contains histamine, IL-4, -13 and vascular endothelial growth factor. Release large quantities of cytokines. Regulates Th cells and induce B cell IgE synthesis. Initiates allergic inflammation
Mast cell
Not considered a leukocyte. Progenitors originate in BM but are released into blood where they migrate to tissue destination to mature. Effector cells in allergic reactions. Antigen presenting cells. Can both enhance and suppress immune response. Gatekeepers to mucosal surfaces.
Monocyte
Developed in BM. No storage pool in BM - released into PB upon maturation, though pool of immature monocyte may exist in spleen. Exist in PB as circulating and marginal pool. Development similar to neut as both derived from GMP. M-CSF (macrophage) is the major cytokine responsible for growth and differentiation. Developmental stages include monoblast, promonocyte, monocyte - eventually enter tissues and become macrophages
Innate immunity
Monocyte/macrophages recognize bacterial pathogens and stimulate inflammatory cytokine production and phagocytosis. Macrophage can synthesize nitric oxide - toxic against viruses, bacteria, fungi, protozoa, helminths and tumor cells. Both have Fc receptors and complement receptors to allow for phagocytize of foreign organisms coated with antibodies or complement components.
Adaptive immunity
Macrophage act as antigen presenting cells. Interact with and activate both T and B cells to initiate response. Engulf foreign material, process and display peptide on membrane to present it to T cells.
Monocyte/macrophage Housekeeping
Removal of debris and dead cells at sites of infection or tissue damage. Destruction of senescent RBC and maintenance of a storage pool of iron for erythropoiesis. Synthesis of wide variety of proteins such as coag factors, complement components, IL, growth factors, enzymes
Lymphocytes
Divided into 3 groups: T cells (adaptive immunity), B cells (adaptive), NK cells (innate). Can be further subdivided to those that participate in humoral immunity (antibody producing like B cells) or those in cellular immunity (attack foreign organisms directly like T and NK cells)
Lymphopoiesis
All 3 types originate in BM. B cells develop in BM to naive B-cells which migrate to lymphoid tissue. T cells lymphoid progenitors migrate from BM to develop in the thymus - eventually leave thymus for secondary lymphatic organs. NK cells can develop in either location
Lymphocyte function
Not end cells, but resting cells - when stimulated, undergo mitosis to produce memory and effector cell. Reticulate from blood to tissues and back to the blood. B and T cells capable of rearranging antigen receptors to produce wide variety of Abs and surface receptor.
B cells
3 to 21% of circulating lymphocytes. Develop initially in the BM and go through 3 stages: Pro-B, Pre-B, immature B cells (naive). Each produce a unique immunoglobulin antigen receptor during these stages. May come in contact with antigen in lymphatic organ or in blood, resulting in cell division and production of memory and effector cell. When exposed to antigen they transform, proliferate and migrate further into medulla of lymph node. Activated cells transform to memory or plasma cells
Plasma cells
Activated B cells. Produce immunoglobulin and proliferate into clone of antibody producing cells or memory cells. Not seen in PB - produced in tissues. Eccentric nucleuswith nuclear halo and a very basophilic cytoplasm
T cells
51 to 88% of circulating lymphocyte. Subdivided into CD4+ or CD8+. Apoptosis occurs in thymic medulla to any cells that may not recognize self-antigen. remaining immature cells then leave thymus and migrate to secondary lymph organ → comes in contact with antigen → activation and produces either memory, effector or both.
T cell development
BM stem cell travels to thymus and population then proliferate in thymus and matures through stages and into various subsets (Pro-T, Pre-T, immature T). Longer life span than B-cells and continuously migrate back and forth from blood to lymphoid tissue.
Helper T cells 1 (TH1)
CD4+ lymphocytes that mediate immune response against intracellular pathogens
Helper T cells 2 (TH2)
CD4+ lymphocytes that mediate hose defence against extracellular parasites including helminths. Also important in induction of asthma and orther allergic diseases
Helper T cells 17 (TH17)
CD4+ lymphocytes that are involved in the immune responses against extracellular bacteria and fungi
Regulatory T cells (Treg)
CD4+CD25+ lymphocytes that play a role in maintaining self-tolerance by regulating immune reponse. Release chemicals to suppress the activity of T and B cells. Stop the immune reponse to prevent uncontrolled activity.
Cytotoxic T cells (Tc)
CD8+ lymphocytes that are capable of killing target cells by secreting granules containing granzyme and perforin or by activating apoptotic pathways in target cells.
NK cells
Function as part of innate immunity. Capable of killing certain tumor cells and virus infected cells without prior sensitization. Recognize the lack of self-antigens on foreign surface. Can kill tumor and virus infected cells by releasing perforins. Modulate the function of other cells, including macrophages and T cells
Coulter principle of impedance
WBC suspended in electrically conductive diluent as cells pass through counting chamber with small applied current, disrupting current flow which creates measureable voltage pulse. # of pulse = # of cells counted and pulse size = cell size
VCS 360 technology
Volume analysis (V): uses low freq current to generate crude WBC count
Conductivity analysis (C): uses high freq current to assess nuclear constituents of cell
Light scatter analysis (S): uses laser light scatter to assess the granularity of the cell
DxH 690T
Automated CBC analyzer. WBC count and diff performed using combination of Coulter principle and VCS technology
DxH 560
Automated CBC analyzer. Uses Coulter principle to measure WBC count. Uses combination of impedance data and direct optical measurement (blue LED) to generate 5-part diff.
Neonatal
First 4 weeks of life
Infancy
up to 1 year
Childhood
1 year to puberty (8 to 13 yrs)
Pediatric CBC parameters
RBC, hgb and HCT increased at birth due to elevated EPO, gradual decline over first 4-6 weeks with very thick blood. PLT comparable to adult values but with greater variation in diameter in shape and hypofunctional compared to adults
Neonatal RBC morph
Markedly macrocytic until day 5 of life. NRBC common on day 1, disappear by day 3 to 4 - presence after day 5 indicates potential critical illness. Increased poly at birth with retic count of 4-6% which decreases. Increased burr cells, sphero, stomatocytes compared to adults. Elevated RDW (up to 18%), normalized by 6 months
Pediatric RBC disorder
IDA is most common pediatric hematologic disorder and leading cause of childhood anemia. If anemia is suspected, diagnosis involves specialized test and reference range may differ from adults. DAT and ABO/Rh tests for HDN, hgb electrophoresis and HPLC for hemoglobinopathies or thalassemia, PBS for RBC membrane defects, enzyme assays for G6PD or PK def.
Pediatric WBC parameter
Leukocytosis at birth with increase in segmented neut, bands and occ metamyrelocyte. Neutrophilia is normal at birth, however decreased segmented neut with increased band and meta with morph changes indicates infection. Mono count higher than adult at birth, increases during weeks 2-3 with increased vacuolization then decline to adult levels by 3-5 months. Eos and baso count remains consistent
Reverse ratio / inverted diff
By 1 year of age, the lymphocyte percentage in pediatrics almost double the neut percentaged. Considered normal. Will slowly decrease after year 3.
Hematogones
benign immature B cells in newborn blood, can be mistaken for blasts
Pediatric immune response
Decreased responsiveness to antigens due to poor antigen presentation by monocytes and inhibition of neut response. Infection is suspected if increased band count, high immature to total neut ratio, and any morphological indicators of infection
Geriatric BM changes
Cellularity declines predictably with age due to reduced trabecular bone volume and increased marrow fat. Telomere shortening may impact hematopoietic stem cell differentiation
Geriatric CBC parameter
Most RBC parameters dont show significant deviations from adults, however gradual decline of RBC count and hgb noted. PLTs decline in advanced age and becomes hyperactive with increased risk of thrombosis.
Geriatric RBC disorder
Anemia is common in the elder pop, often unexplained anemia of aging. Other causes includes anemia of inflammation (or anemia of chronic disease) and ineffective erythropoiesis
Geriatric WBC parameter
No difference compared to the count and diff of adult - however immune response is compromised: more susceptible to infection, take longer to recover and shows delayed immune response.
Geriatric immune response
Number of naive T cells decrease and increase dependence on memory T cells due to thymic atrophy along with decreased B cell precursor and HSC wanting to produce myeloid cells increases morbidity of infectious agent in elderly. Macrophage and mono dysfunction also increases with aging process.
Hematologic neoplasia
Most common form in children is acute lymphoblast leukemia (ALL). Most common form in elderly are myelodysplastic neoplasms, myeloproliferative neoplasms, chronic lymphocytic leukemia (CLL)
Benign absolute neutrophilia
Shifts in neuts from marginal into circulatory pool due to stress, trauma, labor, strenuous exercise, shock, burns or increase in epinephrine.
Pathological absolute neutrophilia
Shift in neuts from marginal into circulatory pool alongside increased BM production and release of neut from storage pool to PB due to infection
Left shift
Describes an increased number of immature cells as an indicator of infection. Increase in bands, metamyelocytes (possible myelocytes or even more immature forms). Increased release from storage pool. Usually seen in neutrophilia and toxic changes
Leukemoid reaction
A reactive leukocytosis above 50 × 109/L with neutrophilia and a marked left shift. Bands and often metas/myelo are seen with rare pro or blast. Caused by severe or chronic infection such as TB/pneumonia, severe hemolysis/hemorrhage, malignancy, severe burns or trauma, medications or toxins and inflammatory conditions
Leukoerythroblastic picture
Presence of immature neutophils and nucleated RBC on the PBS. Points to possibility of space-occupying lesion in BM such as metastatic tumor, fibrosis, lymphoma, leukemia or simply marked increase in a normal marrow cell. Strongly associated with primary myelofibrosis esp when accompanied with tears.
Absolute neutropenia
Caused by increased rate of removal or destruction, decreased production or ineffective hematopoiesis, decreased ratio of circulating vs marginal pool, depletion of BM storage, or BM suppression due to some acute leukemias or aplastic anemia.
Eosinophilia
Absolute count > 0.4 × 109/L. Caused by allergies (asthma), parasitic infection, some autoimmune disorder, congenital immunodeficiency syndromes, radiation exposure, hematologic malignancies, solid tumors, primary eosinophilic disorder
Basophilia
Absolute count >0.15 × 109/L. Non malignant causes include hypersensitivity reactions, hypothyroidism, chronic inflammation. Also caused by malignant myeloproliferative neoplasms like chronic myelogenous leukemia.
Hypersegmentation
acquired non-malignant qualitative nuclear abnormality. Over 5 segments. Occurs in chronic infections, megaloblastic anemia, or drugs,
Hyposegmentation
acquired non-malignant qualitative nuclear abnormality. Bilobed or no segmentation. Occurs in myelodysplastic syndromes (MDS) - asynchrony of nuclear maturation causing very clumped chromatin and no segmentation.
Pyknotic cells
acquired non-malignant qualitative nuclear abnormality. Dying cells. Nucleus is very dark/dense with filament that are still visible.
Necrotic cell
acquired non-malignant qualitative nuclear abnormality. Dead cells with very dense nucleus with no visible filaments.
Mitotic cells
Usually only seen in BM. Not an abnormality - just a phase. Not counted in diff - stage cannot be identified
Toxic granulation
acquired non-malignant qualitative cytoplasmic abnormality. Stress response to infection / inflammation. Clinically significant - marker of inflammation.
Toxic vacuolization
acquired non-malignant qualitative cytoplasmic abnormality. Neutrophils contain several vacuoles. Often seen with toxic granulation. Some can spontaneously occur. Can indicate phagocytosis. May contain bacteria and other material
Dohle bodies
acquired non-malignant qualitative cytoplasmic abnormality. Pale blue, oval inclusions at the periphery of neuts. Remnants of ribosomal RNA or RER. Associated with bacterial infection, sepsis/severe or systemic infection, pregnancy, burns/trauma, malignancy, G-CSF
Lupus Erythematosis (LE) cell
A mature neutrophil which has phagocytized a spherical homogeneous appearing inclusion. Inclusion is nuclear material of degenerating leukocytes coated with antinuclear antibody. Associated with SLE and some other autoimmune conditions. Segments are stretched around phagocytosed nucleus. Protein in engulfed nucleus is depolymerized by antibody and appears homogeneous.
Auer rod
Not a non-malignant change. Only seen in blasts and promyelocytes in acute leukemia. Only seen in myeloblasts - not lymphoblasts. Fused primary granules forming azurophilic rods.
Pelger-Huet Anomaly
Present as hyposegmentation of neutrophil nucleus. Autosomal dominant and asymptomatic. Mature cells have exceptionally coarse nuclear chromatin and condensed. In heterozygous state nucleus is bi-lobed with dense heterochromatin and incomplete nuclear segmentation (dumbbell shaped). In homozygous state nucleus is round or oval with no segmentation
Pseudo-Pelger-Huet
Condition induced by drug. Seen in patients with HIV, TB and mycoplasma pneumonia, severe bacterial infections. Secondary to myelodysplastic syndromes, acute leukemias and chronic myeloproliferative disorders. Usually accompanied by other abnormal changes
Alder-Reilly anomaly
Autosomal recessive. Abnormally large, deep purple, metachromatic granules in the cytoplasm of granulocytes, monocytes, lymphocytes. Incomplete degradation of mucopolysaccharides, forming deposits in most cells. May resemble promyelocytes or heavy toxic granulation. Leukocyte function is unaffected
May-Hegglin Anomaly
Autosomal dominant PLT disorder. Leukopenia with large basophilic inclusions. Variable thrombocytopenia with giant forms, may be hypogranular. Inclusion similar to Dohle bodies except seen in all granulocytes and mono, composed of precipitated myosin heavy chains, larger than ones in infection and permanent, not transient, not seen with other toxic changes. Usually asymptomatic or have mild bleeding disorder
Chediak-Higashi syndrome
Autosomal recessive. Characterized by abnormal fusion of granules in most cells that contain granules throughout the body. Fused granules are large and mostly dusfunctional. Hematopoietic cells affected. Dysfunctional phagocytosis and inefficient bacterial destruction causing increased susceptibility to infection and cytopenias
Chronic granulomatous disease
Rare X-linked or autosomal recessive. Neutrophil morphology is usually normal. Decreased ability to phagocytes to produce NADPH oxidase. Causes recurring bacterial and fungal infections as bacteria are not killed on ingestion and remain encased in granulomas which can rupture and release live bacteria and pus. Diagnosed with Nitroblue tetrazolium reduction test or flow cytometry.
Leukocyte adhesion disorder (LAD)
Autosomal recessive disorder. Mutation in selectins, integrins or supporting molecules which traps neutrophils in circulation and unable to migrate to site of infection. Causes decreased neutrophil adhesion, impaired bacterial recognition and defective signaling. Absolute neutrophilia seen
Myeloperoxidase deficiency (MPO)
Decreased microbicidal activity. Patients usually asymptomatic but still susceptible to infection especially fungal infection. Diagnosed by hematology analyzer unable to detect neutrophil population - unstained cell error, cytochemical staining, flow cytometry, genetic testing.